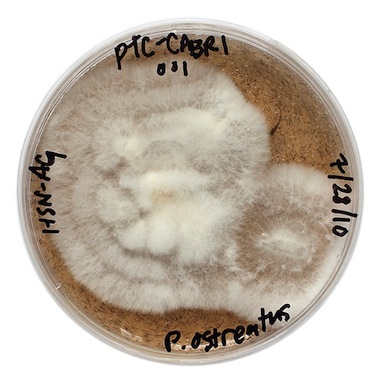
Jae-Rhim-Lee-Infinity-Mushrooms Jae-Rhim-Lee-Infinity-Mushrooms

3.16 / Nomadic Tendencies
Species Being
May 31, 2012
Image: Jae Rhim Lee. "Decompiculture Kit" from Infinity Burial Project, 2009-present; capsules, biological elements, non-toxic chemicals, and odors. Courtesy of the Artist.
Friendship is not a gift, or a promise; it is not a form of generosity. Rather, this incommensurable relation of one to the other is the outside drawing near in its separateness and inaccessibility. Desire, pure impure desire, is the call to bridge the distance, to die in common through separation. Death suddenly powerless, if friendship is the response that one can hear and make heard only by dying ceaselessly.
—Maurice Blanchot, The Writing of the Disaster1
A powdery, odorous mixture rests inside convex, oblong capsules of clear gel. The sandy-looking substance contains biological elements that accelerate the breakdown of skin, muscle, and bone. Jae Rhim Lee, who developed the cocktail as part of her Infinity Burial Project, has also been selectively breeding edible fungi such as shiitake and oyster mushrooms to consume her own tissue and excrement, choosing the ones that thrive off of fingernail clippings, hair, cuticles, and sweat to mate with others that have similar affinities. The resulting “Infinity Mushroom” spores and encapsulated “Decompiculture Kit” will eventually be incorporated into burial products designed to accelerate decay while cleansing postmortem human clients of the hundreds of toxins that they accumulate during life.
The Infinity Burial Project proposes a reconsideration of death’s definition as permanent, disastrous cessation, insisting instead that the unresponsive corpse is a site of productivity. It tears into ontological divides between life and death, activity and passivity, human and non-human, utility and aesthetics, art and life. When a work is embedded in the world, trying to determine which parts are the art parts is something like trying to distinguish where cultivation stops and where decomposition begins. “Decompinauts,” a network of people who have joined Lee’s “Decompiculture Society,” grow fruiting bodies, which in turn help to sustain the human species by remediating pollutants in the soil. The symbiotic knot joining human and mycological production is tied so tightly that our ontologies begin to fuzz.
Donna Haraway has formalized the dependent foundations of species identity in her Companion Species Manifesto, writing, “Through their reaching into each other, through their ‘prehensions’ or graspings, beings constitute each other and themselves. Beings do not preexist their relatings.”2 Though the impulse is to differentiate and categorize, the same formulations that separate one kind of being from another also require the two to be drawn together in the same breath, sentence, or thought. For an exhibition entitled Death: The Last Taboo (2009), the Australian Museum noted that only humans memorialize a life’s passing: “While there is evidence that some animals are aware of death and even mourn their dead, humans are the only species who mark the event.”3 Animals mourn; humans mark.
In the Economic and Philosophic Manuscripts, Karl Marx uses the term “species being” to denote human essence, a universal core which connects us to one another and to nature; it is “life-begetting life,” a basic sociality realized through a distinctly human mode of production, which he calls “free conscious activity.”4 Marx articulates this essential being by outlining a distinction: “An animal produces only itself, whilst man reproduces the whole of nature.”5 In his view, animals build to fulfill basic needs, whereas humans also apply meanings to the

Mikey Siegel. Prototype illustration for Jae Rhim Lee's "Mushroom Death Suit" from Infinity Burial Project, 2009-present. Courtesy of the Artist.
things we make and make certain things solely because they mean something:
Animals produce only according to the standards and needs of the species to which they belong, while man is capable of producing according to the standards of every species and of applying to each object its inherent standard; hence, man also produces in accordance with the laws of beauty.6
In other words, animals produce out of exigency, whereas humans only truly produce as humans when they do so freely, aesthetically rather than pragmatically.
Though universalizing, Marx’s idea of essence is contingent at its core, constituted by its limit and counterpoint. When he parses methods of making in order to establish characteristics common to the human species, it’s in contradistinction to an animal other. His assertion that only humans are capable of unfettered creative output requires non-human producers to give it meaning. Marx’s human/animal opposition also implies other, equally forceful binary gulfs: free versus need-based creation, utility versus beauty, practical versus aesthetic forms. These are some of the same distinctions drawn between socially engaged art and non-socially engaged art, and between socially engaged art and socially engaged non-art.
A work that meets a social need is perhaps most readily identified as social work, or socially engaged non-art. Socially engaged art, in contrast, is not bound by the requirement to create a tangible effect. This distinction derives from the opposition between aesthetic and useful production. A work’s ability to function as a proposal is put at odds with its practical implementation; its value as an artwork is considered apart from its value as a vector in the real world. Though limiting, the distinction serves a purpose. To call an action an art action can allow for experimentation, enable funding without a demand for concrete effect, and foster activities that are unallowable in other frameworks.7 When the division between art and non-art collapses entirely, art-like forms can be co-opted, almost imperceptibly, in support of a brand. To demand of art a predictable, consistent product would be to subordinate creation to consumption.
Jae Rhim Lee. "Infinity Mushroom" from Infinity Burial Project, 2009-present; mushroom spores in culture. Courtesy of the Artist.
Rather than eradicating distinction, the aim of and method behind breaking down a binary is to show the trust between its two parts. While the Infinity Burial Project centers on types of production and their value, it complicates the differentiation Marx puts in place between humans and other organisms by specifying the ways in which their distinct modes of making are interrelated. The mushrooms Lee trains to consume her sloughed skin ordinarily enter into relationship with humans through the mouth. By choosing the mushroom as her decomposer rather than a worm, maggot, or beetle, she alters a widely accepted understanding of the mushroom as something one ingests, making it visible as a producer (and consumer) in its own right. She proposes erasure as a type of generation, death denial as a type of life denial. The use of formaldehyde to preserve the appearance of vitality in a corpse not only spurns decomposition but also the generation that happens therein. It refuses a body’s connection to the landscape, to the water table, to root systems, pipelines, and sewers. Allowing for the decay of one’s own body supports a type of production that does not fulfill an immediate bodily need but a social one, shared across species.
Lee has presented her project as “A Modest Proposal for the Postmortem Body,” relating it to Jonathan Swift’s 1729 “A Modest Proposal for Preventing the Children of Poor People From Being a Burden on Their Parents or Country, and for Making Them Beneficial to the Publick.” Swift’s suggestion for enhancing the social efficacy of a child born into an impoverished family is to tack on a use and exchange value; the parents, he submits, should sell their babies to the wealthy, for whom they’ll function as food. Though Lee’s professed kinship with Swift’s satire suggests that the actual implementation of the Infinity Burial Project might not be essential to its impact, members of the Decompiculture Society frequently express interest in purchasing her “Mushroom Death Suit,” still a prototype. They’ve asked if they can offer their bodies to the project, evidencing a firm conviction that the project should meet its ends.
A work can be beautiful in its practical application. But a proposal can also be useful, whether or not it can effectively be applied as proposed. There’s no need to detach “free conscious activity” from its impact. There is, however, a need to understand that these prefigured types are tangled, to stop using binary oppositions as shorthand. Definitions serve to structure and support practices. Whether those practices deconstruct intricate cultural assumptions or build cost-benefit analyses, we have to be vigilant about how they claim and are claimed by categories. We need to ask how the word art is being applied without becoming asphyxiated by its ontology, without being consumed by the question, “Is that thing art at the level of its being?” This involves cultivating a studied decomposition while preserving certain distinctions, sometimes for their own sake, and sometimes because they have a use.
The Infinity Burial Project is profiled in Landfill Quarterly Issue 3: “Species Being.”
________
NOTES:
1. Maurice Blanchot, The Writing of the Disaster, trans. Ann Smock (Lincoln: University of Nebraska Press, 1995), 29.
2. Donna Haraway, The Companion Species Manifesto: Dogs, People, and Significant Otherness (Chicago: Prickly Paradigm Press, 2003), 6.
3. Australian Museum, “Disposing of the Dead,” http://australianmuseum.net.au/Disposing-of-the-dead. Accessed May 28, 2012.
4. Paul Santilli, “Marx on Species Being and Social Essence,” Studies in Soviet Thought 13, no. 1/2 (June 1973): 76.
5. Karl Marx, Economic and Philosophic Manuscripts of 1844, trans. Martin Mulligan (Moscow: Progress Publishers, 1959).
6. Ibid.
7. The Infinity Burial Project has received arts funding from the Creative Capital Foundation, the Institüt für Raumexperimente/Universität der Künste Berlin, and the MAK Center for Art and Architecture. It has also been fostered by the TED Fellows program.